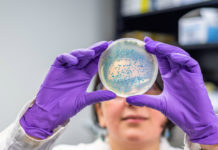
Patent till Umeåforskning för ny klass av antibiotika Läkemedelsvärlden

En ny svensk studie från Umeå universitet visar att injektioner med mistelextraktet Iscador inte förlänger livet för patienter med avancerad bukspottkörtelcancer.
Den nya studien är publicerad i den vetenskapliga tidskriften Aerzeblatt.
Kathrin Wode, specialistläkare i onkologi och palliativ medicin vid institutionen för diagnostik och intervention vid Umeå universitet, är försteförfattare och studieledare.
Hon berättar att forskarna verkligen hoppats att mistelextrakt skulle kunna hjälpa den här mycket utsatta patientgruppen.
– Bukspottkörtelcancer är en svår sjukdom att behandla. Det är otroligt efterlängtat att hitta behandlingar, säger Kathrin Wode till Läkemedelsvärlden.
Upptäcker ofta cancern sent
Bukspottkörtelcancer är en av de mest dödliga cancersjukdomarna.
– Ofta går det inte att försöka bota cancern, utan det handlar om att vinna tid. Många gånger upptäcker man den så sent att den redan spritt sig vilket gör att cancer inte kan opereras bort, berättar hon.
En stor andel drabbade är i dåligt skick, gamla och sjuka, när läkare väl diagnosticerar cancern.
Behandlingsmöjligheterna är få. De starka cytostatikakombinationer (cellgifter) läkare kan pröva att behandla cancern med kräver att patienten är i god kondition.
Men eftersom man ofta upptäcker cancern sent klarar många patienten inte de starka cellgiftskombinationerna som kan förlänga livet. Bukspottkörtelcancer svarar heller inte på immunterapier.
Studerar om mistelextrakt förlänger livet
Prognosen för patienter med bukspottkörtelcancer är mycket dålig. Utan cytostatikabehandling överlever patienten omkring två månader. Patienter med tillräckligt bra allmäntillstånd för att tåla cytostatikabehandling överlever vanligen sex till elva månader.
Det finns flera godkända växtbaserade läkemedel med mistel. Iscador är det mest kända läkemedlet med mistelextrakt. I den aktuella studien använde forskarna Iscador Qu.
– Det är det läkemedel som har bäst evidens mot bukspottkörtelcancer enligt tidigare forskning. I en tidigare studie som publicerades 2013 såg man god effekt, överlevnadslängden nästan dubblerades. Det var därför vi valde att titta på just det preparatet, berättar Kathrin Wode.
– Den tidigare studien var dock inte blindad och den genomfördes i Serbien där vården skiljer sig åt från Sverige. Det var en så kallad open label studie. Med det menas att patienterna visste om att de fick mistelextrakt.
Får sprutor med mistelextrakt
De svenska forskarna ville se om de kunde bekräfta de positiva resultaten från den serbiska studien.
Den nya svenska studien är både randomiserad, placebokontrollerad och dubbelblind, berättar Kathrin Wode. Det betyder att forskarna lottar försökspersonerna till att endera få mistelextrakt eller till att få placebo.
Vid en dubbelblind studie vet varken patienterna själva eller forskarna vem som har fått verksam substans förrän studien är klar.
Alla patienter i studien fick även standardbehandling, det vill säga cytostatika, eller enbart symtomlindring.
I studien lottas 143 patienter till att få injektioner med mistelextrakt och 147 till att få injektioner med placebo. Sprutorna gavs tre gånger i veckan under nio månader.
Bekräftar inte tidigare studie av mistelextrakt
Resultaten visar att medelöverlevnaden hos patienterna med avancerad bukspottkörtelcancer är åtta månader. Det spelar ingen roll om de lottas till att få mistelextrakt eller placebo. Det finns ingen statistiskt säkerställd skillnad mellan grupperna.
Men varför visar er studie inte på förlängd överlevnad, när den tidigare studien gjort det?
– Det undrar vi hela artikeln igenom! Vi har sökt efter alla tänkbara felkällor. Men studien är rigorös och våra data gedigna. Jag är trygg med att våra resultat återspeglar överlevnaden.
– Det är en stark studiedesign. Studien är heller inte finansierad av något bolag.
För att ytterligare försäkra sig om att resultaten är riktiga jämför forskarna skillnader i sin patientgrupp jämfört med patienterna i den serbiska studien.
Det gör forskarna exempelvis genom de analyserar data om patienter som liknar dem i undersökningen som tvärtemot visade att mistelextrakt ger förlängd överlevnad.
– Men vi såg ingen effekt där heller, konstaterar Kathrin Wode.
Hoppades på mistelextrakt
Kathrin Wode understryker att forskarna hoppats att mistelextrakt skulle kunna hjälpa den här mycket utsatta patientgruppen.
– Men nu vet vi att mistelextrakt inte gör någon nytta vid bukspottkörtelcancer när det gäller att förlänga livet. Fast det är inte skadligt att ge läkemedlet.
Men egentligen är det inte förvånande att mistelextrakt inte förlänger livet i den här patientgruppen, enligt Kathrin Wode. Mistelextrakt verkar genom att det stimulerar immunsystemet. Något som laboratorie- och djurstudier visar.
För en lekman låter det logiskt att ett immunstimulerande medel har effekt mot cancer, varför är det inte så i det här fallet?
– Olika cancersjukdomar är inte desamma. Just bukspottkörtelcancer producerar ämnen som undertrycker immunsystemet, och det är därför immunterapi inte fungerar. Av den orsaken är det inte jätteförvånande att mistelextrakt inte visar effekt på överlevnaden.
Kanske mistelextrakt förbättrar livskvaliteten?
Forskarna jobbar nu vidare med data från sin studie om mistelextrakt mot avancerad bukspottkörtelcancer.
– Vi arbetar med att analysera data för att se om mistelextrakt förbättrar livskvaliteten, vi hoppas att vi kan publicera de resultaten senare.
Det görs inte så mycket forskning på ämnet, berättar Kathrin Wode.
– Vi anser att det är viktigt att ta patienters intresse för komplementärmedicin på allvar, det var ett av motiven till denna studie. I en värld av konspirationsteorier vill jag understryka att vår intention var att hitta och bekräfta något hoppfullt.
Hur vanligt är det idag att läkare använder mistelextrakt för att behandla cancer?
– Det finns en osäkerhet kring effekten och det saknas praxis. Även om det är ett godkänt läkemedel som läkare får skriva ut upplever jag att det inte är alldeles lätt att hitta läkare som skriver ut det.
Kommer från antroposofisk medicin
Mistelextrakt är utvecklat ur den antroposofiska medicinen. Kathrin Wode anser att läkare som verkar inom detta fält oftare skriver ut sådana läkemedel.
Jag har förstått att mistelextrakt har använts och används även mot andra cancerformer. Vad finns det mer för forskning som är angelägen att göra?
– Vår studie svarar inte på frågan om mistelextrakt förlänger livet vid andra cancerformer.
– Sen vet vi att många kvinnor med bröstcancer använder komplementärmedicin, exempelvis mistelextrakt. Det finns en del data, men ingen studie av den kvaliteten där man har en dubbelblind design och testar överlevnad. Inom det området vore det särskilt angeläget att få veta mer, avslutar Kathrin Wode.